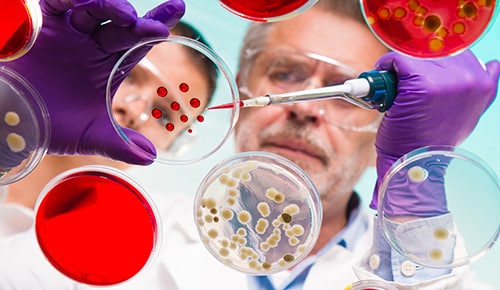
formation Master Chimie Analytique, Physique et Théorique en alternance à la Sorbonne

Pourquoi cette formation ?

Julie BIENTZ
Chargée de missions apprentissage
06 81 45 52 73
j.bientz@afi24.org
Date d'enregistrement certification RNCP : 01/03/2024 | RNCP38703 | Code diplôme : 13511614
Inscription : 15/01/2025 - fin des inscriptions : 13/06/2025 Rentrée : 08/09/2025 Durée de la formation : 340 heures / 1 an
Rythme d'alternance
Période 1(mi-septembre à mi-janvier) : alternance par semaine 2 jours en entreprise et 3 jours à SU.
Période 2(mi-janvier à fin août) : temps plein en entreprise (sauf éventuellement des jours de seconde session) = soit environ 190 jours en entreprise / 50 jours à SU).
Contact établissement
Julie OBLE
Responsable de la formation
julie.oble@sorbonne-universite.fr
Héloïse DOSSMANN
Responsable de la formation
heloise.dossmann@sorbonne-universite.fr
Conditions d'inscription
Jeune ayant moins de 30 ans à la signature du contrat d'apprentissage.
Master 1 de chimie.
De solides bases et compétences sont exigées en chimie des matériaux, chimie moléculaire, ingénierie chimique ou physico-chimie (en fonction du domaine de spécialisation choisi par l’étudiant).
L’évaluation du dossier tient compte également des critères suivants : interdisciplinarités des études, stages, mobilité géographique, accomplissements personnels significatifs, langues…
Modalités
Modalité(s) d'évaluation :
Evaluation répartie : contrôle continu, TP, présentation par affiche, rédaction d’un rapport, soutenance orale.
Modalités pédagogiques :
Cours théoriques / Travaux pratiques / Travaux dirigés
Procédure de recrutement :
Etude du dossier : CV, lettre de motivation, relevés de notes de l'année en cours. Les relevés de notes des l'années précédentes sont vivement conseillés.
Entretien de motivation.
1. Candidature sur dossier (CV, lettre de motivation, relevés de Notes) sur le site de l'AFI24 ;
2. Candidature à Sorbonne Université sur le site e-candidat.
| Résultat examen : | 94% | |
| Poursuite d'études : | 16% | |
| Insertion professionnelle : | 94% | |
| Rupture de contrat : | 8% | |
| Rupture de parcours : | 5% |
Les métiers visés : Master Chimie analytique, physique
Objectifs de formation : Master Chimie analytique, physique
Programme : Master Chimie analytique, physique
- ANNÉE 2
Une année de formation à 60 ECTS : 30 ECTS pour la formation à Sorbonne Université, 30 ECTS pour la formation en entreprise.
L'évaluation des 60 crédits ECTS correspondant à une charge de travail à temps plein sur une année universitaire est encadrée par des dispositions juridiques nationales. En général, cette charge de travail se situe entre 1 500 et 1 800 heures par an, ce qui signifie qu’un crédit ECTS correspond à 25 à 30 heures de travail (incluant enseignement synchrone, asynchrone et travail personnel) — Guide d’utilisation des ECTS 2015 (ec.europa.eu/education/tools/ects_fr.htm).
La deuxième année du master de chimie est découpée en 2 blocs de compétences qui doivent chacun être validés pour obtenir le diplôme de master.
1er bloc de compétences : spécialisation (30 ECTS) – de septembre à janvier
- Quatre unités d’enseignement (UEs) de 6 ECTS sont choisies parmi celles proposées dans les 4 domaines MAT, MOL, IC et CAPT.
Quelques exemples d’UEs :
MAT : Applications industrielles de systèmes polymères complexes / Propriétés mécaniques des matériaux solides / Formulation des dispersions colloïdales et des systèmes assemblés / Physico-chimie des polymères / Synthèse macromoléculaire avancée / Matériaux pour un monde durable / Nanosciences et nanotechnologies : des concepts aux applications / Matériaux pour la catalyse : synthèse et réactivité / Revêtements et nanomatériaux supportés …
MOL : Molécules naturelles et/ou bioactives – Méthodes et stratégies de synthèse / Espèces hautement réactives en synthèse organique / RMN et spectrométrie de masse en chimie analytique et chimie moléculaire / Cibles thérapeutiques : approches moléculaires / Catalyse organométallique pour la synthèse / Méthodologies innovantes pour une chimie durable / Chimie supramoléculaire / Assemblages nanométriques fonctionnels…
IC : Management des risques chimiques industriels / Outils numériques pour l'ingénierie chimique / Optimisation et contrôle des procédés / Procédés et développement durable / Procédés industriels et traitement de surface pour l’élaboration de matériaux innovants / Bioprocédés / Catalyse hétérogène pour l’énergie et l’environnement…
CAPT : Chimie analytique et bioanalyse (I) : Méthodes séparatives avancées et chimiométrie / Chimie analytique et bioanalyse (II): Séparations multidimensionnelles, bioessais et miniaturisation / Modélisation multi-échelles des systèmes moléculaires complexes / Caractérisation et imagerie des systèmes complexes ou formulés / Spectroscopies X-UV et microscopie électronique : méthodes avancées pour l’étude de la réactivité…
- Une UE de 6 ECTS « Projet expérimental de spécialisation en entreprise » – deux jours par semaine de début septembre à fin janvier. Ce projet est évalué par une présentation sur affiche en janvier.
2ème bloc de compétences : compétences en entreprise (30 ECTS) – de janvier à septembre
Ce bloc correspond à la partie de la formation par apprentissage en entreprise à temps plein de fin janvier à fin août. L’évaluation consiste en la remise d’un rapport et sa soutenance en septembre (27 ECTS).
Des « formations transversales pour l’entreprise » sont aussi dispensées au 2ème semestre durant 1 semaine (3 ECTS) : passage du TOEIC, formation HSEQ et passage du brevet de Secourisme et Santé au Travail (SST).
Notre groupe biopharmaceutique développe, fabrique et commercialise des médicaments dérivés du sang et des protéines recombinantes pour la prise en charge des patients atteints de pathologies graves et souvent rares.
Nous recherchons pour notre site...